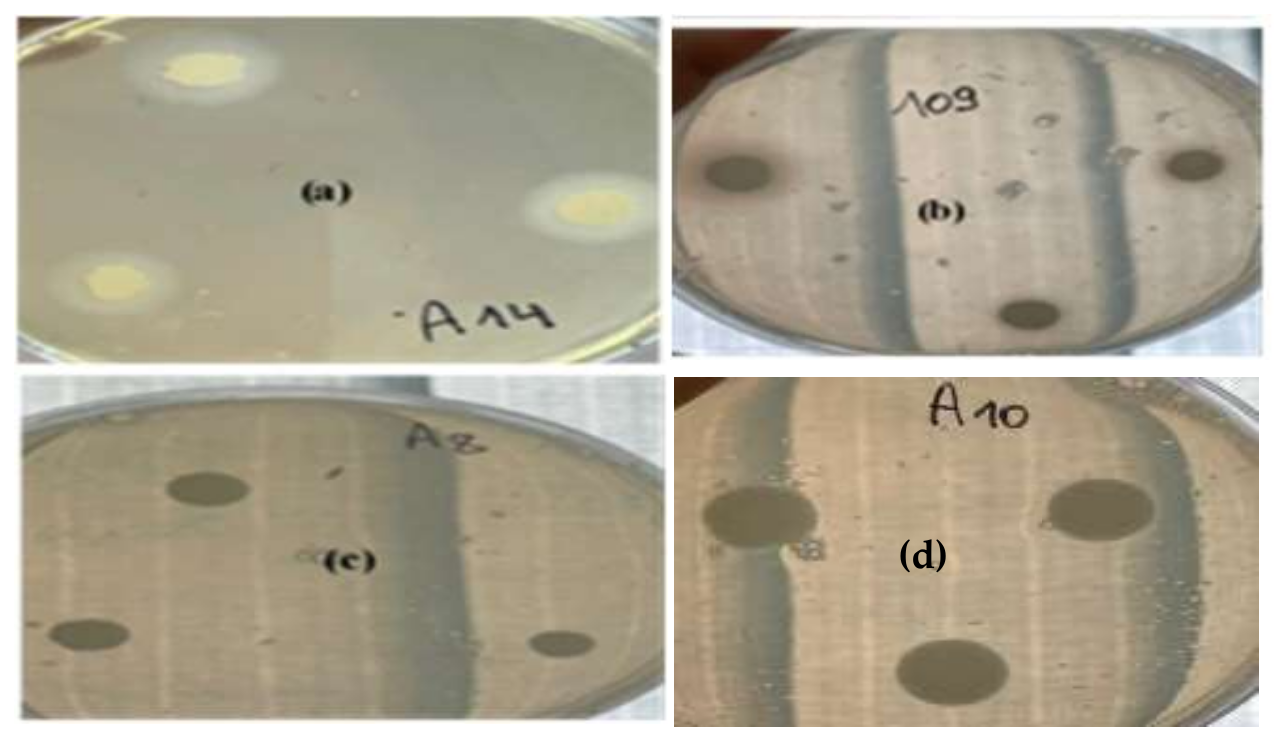
Life 12 01756 g001

Antibiofilm Potential and Exoenzyme Inhibition by Elattaria cardamomum Essential Oil in Candida spp. Strains
Abstract
1. Introduction
2. Materials and Methods
2.1. Patients, Strains, Media, and Growth Conditions
2.2. Phospholipase Assay
2.3. Proteinase Assay
2.4. Qualitative Detection of Exopolysaccharide Production
2.4.1. Safranin Method
2.4.2. Detection of Slime Production by the Congo Red Agar (CRA) Method
2.5. Biofilm Formation on Polystyrene
2.6. Plant Material and Extraction of Essential Oil
2.7. Composition of Elattaria Cardamomum Essential Oil
2.8. Effect of Elattaria Cardamomum Essential Oil on Candida strains
2.8.1. Disk Diffusion Assay
2.8.2. Minimum Inhibitory and Minimum Fungicidal Concentrations
2.9. Effect of E. Cardamomum EO on Enzymatic Activities
2.10. Anti-Biofilm Activity of E. cardamomum EO
2.11. Statistical Analysis
3. Results
3.1. Enzymatic Characterization
3.2. Chemical Composition of E. cardamomum EO
3.3. Antifungal Activity of E. cardamomum EO
3.4. Anti-Enzymatic Activity of Green Cardamom EO
3.5. Adhesive Properties and Biofilm Formation
3.6. Antibiofilm Activity of E. cardamomum EO
4. Discussion
5. Conclusions
Author Contributions
Funding
Institutional Review Board Statement
Informed Consent Statement
Data Availability Statement
Conflicts of Interest
References
- Ramage, G.; Bachmann, S.; Patterson, T.F.; Wickes, B.L.; Lopez-Ribot, J.L. Investigation of multidrug efflux pumps in relation to fluconazole resistance in Candida albicans biofilms. J. Antimicrob. Chemother. 2002, 49, 973–980. [Google Scholar] [CrossRef] [PubMed]
- Sullivan, D.; Coleman, D. Candida dubliniensis: An emerging opportunistic pathogen. Curr. Top. Med. Mycol. 1997, 8, 15–25. [Google Scholar] [PubMed]
- Bauer, A.W.; Kirby, W.M.; Sherris, J.C.; Turck, M. Antibiotic susceptibility testing by standardized single disc method. Am. J. Clin. Pathol. 1996, 45, 493–496. [Google Scholar] [CrossRef]
- Mane, A.; Kulkarni, A.; Risbud, A. Biofilm production in oral Candida isolates from HIV-positive individuals from Pune, India. Mycoses 2013, 56, 182–186. [Google Scholar] [CrossRef] [PubMed]
- Yigit, N.; Aktas, E.; Dagistan, S.; Ayyildiz, A. Investigating biofilm production, coagulase and haemolytic activity in Candida species isolated from denture stomatitis patients. Eur. J. Med. 2011, 43, 27–32. [Google Scholar]
- Chaffin, W.L. Candida albicans cell wall proteins. Microbiol. Mol. Biol. Rev. 2008, 72, 495–544. [Google Scholar] [CrossRef]
- Antonio, D.; Romani, F.; Pontieri, E.; Fioritoni, G.; Caracciolo, C.; Bianchini, S. Catheter-related candidaemia caused by Candida lipolytica in a patient receiving allogenic bone marrow transplantation. J. Clin. Microbiol. 2002, 40, 1381–1386. [Google Scholar] [CrossRef][Green Version]
- Nobile, C.J.; Johnson, A.D. Candida albicans biofilms and human disease. Annu. Rev. Microbiol. 2015, 69, 71–92. [Google Scholar] [CrossRef]
- Kojic, E.M.; Darouiche, R.O. Candida infections of medical devices. Clin. Microbiol. Rev. 2004, 17, 255–267. [Google Scholar] [CrossRef]
- Arora, D.S.; Kaur, G.J. Antibacterial activity of some Indian medicinal plants. J. Nat. Med. 2007, 61, 313–317. [Google Scholar] [CrossRef]
- Souissi, M.; Azelmat, J.; Chaieb, K.; Grenier, D. Antibacterial and anti-inflammatory activities of cardamom (Elettaria cardamomum) extracts: Potential therapeutic benefits for periodontal infections. Anaerobe 2020, 61, 102089. [Google Scholar] [CrossRef] [PubMed]
- Ashokkumar, K.; Murugan, M.; Dhanya, M.K.; Warkentin, T.D. Botany, traditional uses, phytochemistry and biological activities of cardamom [Elettaria cardamomum (L.) Maton]—A critical review. J. Ethnopharmacol. 2020, 246, 112244. [Google Scholar] [CrossRef] [PubMed]
- Ashokkumar, K.; Murugan, M.; Dhanya, M.K.; Raj, S.; Kamaraj, D. Phytochemical variations among four distinct varieties of Indian cardamom Elettaria cardamomum (L.) Maton. Nat. Prod. Res. 2020, 34, 1919–1922. [Google Scholar] [CrossRef] [PubMed]
- Kaushik, P.; Goyal, P.; Chauhan, A.; Chauhan, G. In Vitro Evaluation of Antibacterial Potential of Dry Fruit Extracts of Elettaria cardamomum Maton (Chhoti Elaichi). Iran. J. Pharm. Res. 2010, 9, 287–292. [Google Scholar]
- Noumi, E.; Snoussi, M.; Alreshidi, M.M.; Rekha, P.D.; Saptami, K.; Caputo, L.; De Martino, L.; Souza, L.F.; Msaada, K.; Mancini, E.; et al. Chemical and Biological Evaluation of Essential Oils from Cardamom Species. Molecules 2018, 23, 2818. [Google Scholar] [CrossRef]
- Noumi, E.; Snoussi, M.; Hentati, H.; Mahdouani, K.; del Castillo, L.; Valentin, E.; Sentandreu, R.; Bakhrouf, A. Adhesive properties and hydrolytic enzymes of oral Candida albicans strains. Mycopathologia 2010, 169, 269–278. [Google Scholar] [CrossRef]
- Davenport, D.S.; Massanari, R.M.; Pfaller, M.A.; Bale, M.J.; Streed, S.A.; Hierholzer, W.J. Usefulness of a test for slime production as a marker for clinically significant infections with coagulase-negative staphylococci. J. Infect. Dis. 1986, 153, 332–339. [Google Scholar] [CrossRef]
- Noumi, E.; Snoussi, M.; Noumi, I.; Saghrouni, F.; Aouni, M.; Valentin, E. Phenotypic characterization and adhesive properties of vaginal Candida spp. strains provided by the CHU Farhat Hached (Sousse, Tunisia). Rev. Iberoam. Micol. 2015, 32, 170–179. [Google Scholar] [CrossRef]
- Noumi, E.; Snoussi, M.; Kammoun, D.; Bakhrouf, A.; Valentin, E. Comparison of the adhesion ability of Candida albicans strains to biotic and abiotic surfaces. Afr. J. Biotechnol. 2011, 10, 977–985. [Google Scholar]
- Council of Europe. European Pharmacopoeia; Maisonneuve: Sainte-Ruffine, France, 1975; Volume 3. [Google Scholar]
- Davies, N.W. Gas chromatographic retention indices of monoterpenes and sesquiterpenes on methyl silicon and carbowax 20M phases. J. Chromatogr. 1990, 503, 1–24. [Google Scholar] [CrossRef]
- Adams, R.P. Identification of Essential Oil Components by Gas Chromatography-Mass Spectroscopy; Allured Co.: Carol Stream, IL, USA, 1995. [Google Scholar]
- Badiee, P.; Badali, H.; Diba, K.; Ghadimi Moghadam, A.; Hosseininasab, A.; Jafarian, H. Susceptibility pattern of Candida albicans isolated from Iranian patients to antifungal agents. Curr. Med. Mycol. 2016, 2, 24–29. [Google Scholar] [CrossRef] [PubMed][Green Version]
- Cuenca-Estrella, M.; Moore, C.B.; Barchiesi, F. Multicenter evaluation of the reproducibility of the proposed antifu gal susceptibility testing method for fermentative yeasts of the Antifungal Susceptibility Testing Subcommittee of the European Committee on Antimicrobial Susceptibility Testing (AFST-EUCAST). Clin. Microbiol. Infec. 2003, 9, 467–474. [Google Scholar]
- Moroh, J.L.; Bahi, C.; Dje, K.; Loukou, Y.G.; Guide Guina, F. Etude de l’activité antibactérienne de l’extrait acétatique de Morinda morindoides (Baker) Milne-Redheat (Rubiaceae) sur la croissance in vitro des souches d’Escherichia coli. Bull. Soc. R. Sci. Liege 2008, 77, 44–61. [Google Scholar]
- Aneja, K.R.; Sharma, C. Antimicrobial potential of fruit extracts of Elettaria cardamomum maton (chhoti elaichi) against the pathogens causing ear infection. Pharmacologyonline 2010, 3, 750–756. [Google Scholar]
- Duarte, M.C.; Figueira, G.M.; Sartoratto, A.; Rehder, V.L.; Delarmelina, C. Anti-Candida activity of Brazilian medicinal plants. J. Ethnopharmacol. 2005, 97, 305–311. [Google Scholar] [CrossRef]
- Eggimann, P.; Garbino, J.; Pittet, D. Epidemiology of Candida species infections in critically ill non-immunosuppressed patients. Lancet Infect. Dis. 2003, 3, 685–702. [Google Scholar] [CrossRef]
- Anonynous, A. World Health Organization summary of WHO guidelines for the assessment of herbal medicines. Gram 1993, 28, 13–14. [Google Scholar]
- Segal, E.; Clad, D. Candida species and Blastoschizomyces capitus. In Topley & Wilson’s Microbiology and Microbial Infections, 9th ed.; Ajello, L., Hay, R.J., Eds.; Arnold Hodder Headline: London, UK, 1998; 423p. [Google Scholar]
- Cox, G.M.; Perfect, J.R. Fungal infections. Curr. Opin. Infect. Dis. 1993, 6, 422–426. [Google Scholar]
- Inci, M.; Atalay, M.A.; Koç, A.N.; Yula, E.; Evirgen, O.; Durmaz, S. Investigating virulence factors of clinical Candida isolates in relation to atmospheric conditions and genotype. Turk. J. Med. Sci. 2012, 42, 1476–1483. [Google Scholar]
- Vijayalakshmi, P.; Thenmozhi, S.; Rajeswari, P. The Evaluation of the virulence factors of clinical Candida isolates and the anti-biofilm activity of Elettaria cardamomum against multi-drug resistant Candida albicans. Curr. Med. Mycol. 2016, 2, 8–15. [Google Scholar]
- Katrien, V.D.; Felipe, V.; Marion, M.G.; Liesbeth, D.; Esther, H.; Mary Ann, J.R.; Greetje, V.V.; Yves, F.D.; Bastiaan, P.K.; Patrick, V.D. Adhesion of Staphylococcus aureus to Candida albicans during Co-Infection Promotes Bacterial Dissemination Through the Host Immune Response. Front. Cell Infect. Microbiol. 2021, 10, 1–14. [Google Scholar]
- Jabra-Rizk, M.A.; Falkler, W.A.; Meiller, T.F. Fungal biofilms and drug resistance. J. Emerg. Infect. Dis. 2004, 10, 14–19. [Google Scholar] [CrossRef] [PubMed]
- Deorukhkar, S.; Saini, S. Evaluation of phospholipase activity in biofilm forming Candida species isolated from intensive care unit patients. Br. Microbiol. Res. J. 2013, 3, 440–447. [Google Scholar] [CrossRef]
- Tsang, C.S.; Chu, F.C.; Leung, W.K.; Jin, L.J.; Samaranayake, L.P.; Siu, S.C. Phospholipase, proteinase and haemolytic activities of Candida albicans isolated from oral cavities of patients with type 2 diabetes mellitus. J. Med. Microbiol. 2007, 56, 1393–1398. [Google Scholar] [CrossRef]
- Saeed, A.; Sultana, B.; Anwar, F.; Mushtaq, M.; Alkharfy, K.M.; Gilani, A.H. Antioxidant and antimutagenic potential of seeds and pods of green cardamom (Elettaria cardamomum). Int. J. Pharm. 2014, 10, 461–469. [Google Scholar] [CrossRef]
- Khan, A.U.; Khan, Q.J.; Gilani, A.H. Pharmacological basis for the medicinal use of cardamom in asthma. Bangladesh J. Pharm. 2011, 6, 34–37. [Google Scholar] [CrossRef]
- Jafri, M.A.; Farah; Javed, K.; Singh, S. Evaluation of the Gastric Antiulcerogenic Effect of Large Cardamom (Fruits of Amomum Subulatum Roxb). J. Ethnopharmacol. 2001, 75, 89–94. [Google Scholar] [CrossRef]
- Huang, Y.B.; Fang, J.Y.; Hung, C.H.; Wu, P.C.; Tsai, Y.H. Cyclic monoterpene extract from cardamom oil as a skin permeation enhancer for indometacin; in vitro and in vivo studies. Biol. Pharm. Bull. 1999, 22, 642–646. [Google Scholar] [CrossRef][Green Version]
- Singh, G.; Kiran, S.; Marimuthu, P.; Isidorov, V.; Vinogorova, V. Antioxidant and antimicrobial activities of essential oil and various oleoresins of Elettaria cardamomum (seeds and pods). J. Sci. Food Agric. 2008, 88, 280–289. [Google Scholar] [CrossRef]
- Rahman, T.; Rahman, K.A.; Rajia, S.; Alamgir, M.; Khan, M.T.H.; Choudhuri, M.S.K. Evaluation of Antidiarrhoeal Activity of Cardamom (Elettaria cardamomum) on Mice Models. Adv. Tradit. Med. 2008, 8, 130–134. [Google Scholar] [CrossRef]
- Cherrat, L.; Espina, L.; Bakkali, M.; Garcia-Gonzalo, D.; Pagan, R.; Laglaoui, A. Chemical composition and antioxidant properties of Laurus nobilis L. and Myrtus communis L. essential oils from Morocco and evaluation of their antimicrobial activity acting alone or in combined processes for food preservation. J. Sci. Food Agric. 2013, 94, 1197–1204. [Google Scholar] [CrossRef] [PubMed]
- Sharma, S.; Sharma, J.; Kaur, G. Therapeutic uses of Elettaria cardamomum. Int. J. Drug. Formul. Res. 2011, 2, 102–108. [Google Scholar]
- Masoumi-Ardakani, Y.; Mandegary, A.; Esmaeilpour, K.; Najafipour, H.; Sharififar, F.; Pakravanan, M.; Ghazvini, H. Chemical Composition, Anticonvulsant Activity, and Toxicity of Essential Oil and Methanolic Extract of Elettaria cardamomum. Planta Med. 2016, 82, 1482–1486. [Google Scholar] [CrossRef] [PubMed]
- Korikontimath, V.S.; Mulge, R.; Zachariah, J.T. Variations in essential oil constituents in high yielding selections of cardamom. J. Plant. Craps 1999, 27, 230–232. [Google Scholar]
- Sasidharan, I.; Menon, A.N. Comparative chemical composition and antimicrobial activity fresh & dry ginger oils (zingiber Officinale roscoe). Int. J. Curr. Pharm. Res. 2010, 2, 40–43. [Google Scholar]
- Suk, S.; Kwon, G.T.; Lee, E.; Jang, W.J.; Yang, H.; Kim, J.H.; Thimmegowda, N.R.; Chung, M.-Y.; Kwon, J.Y.; Yang, S. Gingerenone A, a Polyphenol Present in Ginger, Suppresses Obesity and Adipose Tissue Inflammation in High-Fat Diet-Fed Mice. Mol. Nutr. Food Res. 2017, 61, 1700139. [Google Scholar] [CrossRef]
- Snoussi, M.; Noumi, E.; Dahmani, A.; Flamini, G.; Aouni, M.; Al-Sieni, M.; Al-Sieni, A. Chemical composition and antimicrobial activities of Elettaria cardamomum L.(Manton) Essential Oil: A high activity against a wide range of food borne and medically important bacteria and fungi. J. Chem. Biol. Phy. Sci. Sec. 2015, 6, 248–259. [Google Scholar]
- Chegini, S.G.; Abbasipour, H. Chemical composition and insecticidal effects of the essential oil of cardamom, Elettaria cardamomum on the tomato leaf miner Tuta absoluta. Toxin. Rev. 2017, 36, 12–17. [Google Scholar] [CrossRef]
- Ghadeer, F.M.; Khalid, M.I.; Hana’a, M.G.; Richard, A.H. Stability of Cardamom (Elettaria Cardamomum) Essential Oil in Microcapsules Made of Whey Protein Isolate, Guar Gum, and Carrageenan. J. Food. Sci. 2014, 79, C1939–C1949. [Google Scholar]
- Oubihi, A.; Tarfaoui, K.; Hajib, A.; Harhar, H.; Ez-Zriouli, R.; Atfaoui, K.; Ouhssine, M.; Guessous, Z. Chemical composition and evaluation of the bioactivity of laurus nobilis essential oil from north-west (Morocco). Pharm. Online 2019, 3, 134–142. [Google Scholar]
- Aline, C.G.; Leandra, M.M.; Mayara, F.L.; Marco Cesar, C.G.; Denise, C.E.; Marcio, F.; Rodrigo, S. Antibacterial Activity of Terpenes and Terpenoids Present in Essential Oils. Molecules 2019, 24, 1–12. [Google Scholar]
- Brondani, L.P.; da Silva Neto, T.A.; Freitag, R.A.; Lund, R.G. Evaluation of anti-enzyme properties of Origanum vulgare essential oil against oral Candida albicans. J. Mycol. Méd. 2018, 28, 94–100. [Google Scholar] [CrossRef] [PubMed]
- Lyon, J.P.; dos Santos, F.V.; de Moraes, P.C.; Moreira, L.M. Inhibition of virulence factors of Candida spp. by different surfactants. Mycopath 2011, 171, 93–101. [Google Scholar] [CrossRef] [PubMed]
- Lima, I.O.; Oliveira, R.A.G.; Lima, E.O.; Farias, N.M.P.; de Souza, E.L. Antifungal activity from essential oils on Candida species. Braz. J. Pharm. 2006, 16, 197–201. [Google Scholar] [CrossRef]

| Strains | Species | Phospholipase | Protease | ||
|---|---|---|---|---|---|
| PZ* ± SD* | Activity | PZ* ± SD* | Activity | ||
| A1 | C. utilis ATCC 9255 | 0.67 ± 0.02 a | Strong | 1 ± 0 a | Very low |
| A4 | C. guillermondii ATCC 6260 | 0.55 ± 0.005 a | Very strong | 0.78 ± 0.01 a | High |
| A8 | C. tropicalis ATCC 1362 | 0.49 ± 0.05 a | Very strong | 1 ± 0 a | Very low |
| A14 | C. albicans ATCC 10231 | 0.65 ± 0.017 ab | Strong | 1 ± 0 a | Very low |
| A15 | C. albicans ATCC 20402 | 0.45 ± 0.069 bc | Very strong | 0.77 ± 0 b | High |
| A9 | S. cerevisiae ATCC 20407 | 0.62 ± 0.03 cd | Very strong | 1 ± 0 b | Very low |
| A10 | C. albicans | 1 ± 0 cd | Negative | 1 ± 0 b | Very low |
| 124 | C. albicans | 0.75 ± 0.02 cd | Strong | 1 ± 0 b | Very low |
| C3 | C. albicans | 0.47 ± 0.05 cde | Very strong | 1 ± 0 c | Very low |
| C2 | C. albicans | 0.58 ± 0.09 cde | Very strong | 0.84 ± 0.05 c | Low |
| 109 | C. albicans | 0.76 ± 0.04 cde | Strong | 0.69 ± 0.09 c | Very high |
| 113 | C. albicans | 0.6 ± 0.005 de | Very strong | 0.68 ± 0 c | Very high |
| 104 | C. albicans | 1 ± 0 e | Negative | 1 ± 0 c | Very low |
| 126 | C. albicans | 0.61 ± 0 f | Very strong | 0.65 ± 0.01 c | Very high |
| 104W | C. albicans | 0.58 ± 0.02 fg | Very strong | 0.63 ± 0.12 c | Very high |
| C4 | C. albicans | 0.44 ± 0.005 g | Very strong | 0.8 ± 0.05 c | Low |
| 108 | C. albicans | 1 ± 0 h | Negative | 1 ± 0 c | Very low |
| 118 | C. albicans | 1 ± 0 h | Negative | 1 ± 0 c | Very low |
| C5 | C. albicans | 0.82 ± 0.03 h | Strong | 1 ± 0 c | Very low |
| C1 | C. albicans | 0.62 ± 0.03 h | Very strong | 1 ± 0 c | Very low |
| N | Compound Name | RT* | Amount | Ki* | Kr* |
|---|---|---|---|---|---|
| 1 | Camphene | 13.674 | 0.135 | 869.4876 | 954 |
| 2 | Δ-2-carene | 15.293 | 0.098 | 890.4374 | 1002 |
| 3 | α-phellandrene | 17.682 | 0.856 | 921.3509 | 1002 |
| 4 | α-terpinene | 18.812 | 3.912 | 935.9731 | 1017 |
| 5 | Limonene | 19.864 | 12.598 | 949.5859 | 1029 |
| 6 | γ-terpinene | 21.7 | 1.65 | 973.3437 | 1059 |
| 7 | Mentha-3,8-diene <p-> | 22.444 | 0.265 | 982.971 | 1072 |
| 8 | Mentha-2,4(8)-diene <p-> | 23.953 | 7.649 | 999.0217 | 1088 |
| 9 | Menthatriene <1,3,8-p-> | 25.348 | 0.166 | 1017.716 | 1110 |
| 10 | Camphor | 27.288 | 0.38 | 1043.715 | 1146 |
| 11 | Limonene-1,2-epoxide (Fr.1) | 30.241 | 0.151 | 1083.289 | / |
| 12 | α-terpineol | 31.094 | 0.227 | 1094.72 | 1188 |
| 13 | Fenchyl Acetate | 32.904 | 0.539 | 1113.468 | 1220 |
| 14 | Mentha-1(7),8-dien-2-ol <cis-p-> | 33.596 | 0.379 | 1123.372 | 1230 |
| 15 | Perilla Aldehyde | 35.006 | 0.451 | 1143.552 | 1271 |
| 16 | Isopulegol Acetate | 37.237 | 0.265 | 1175.483 | 1277 |
| 17 | Bornyl Acetate | 37.625 | 5.561 | 1181.036 | 1288 |
| 18 | Terpinen-4-ol Acetate | 38.427 | 0.942 | 1192.515 | 1299 |
| 19 | Pinocarvyl Acetate <cis-> | 40.126 | 0.388 | 1211.981 | 1312 |
| 20 | α-Terpinyl Acetate | 43.06 | 56.499 | 1256.422 | 1349 |
| 21 | 6,8-nonadien-2-one-6-methyl-5-(1-methylethylidene)- | 43.22 | 0.169 | 1258.846 | / |
| 22 | Carvone Hydrate | 45.133 | 1.728 | 1287.822 | 1423 |
| 23 | Cytronellyl Propanoate | 46.602 | 0.395 | 1304.196 | 1446 |
| 24 | Trans-p-mentha-2,8-dienol | 47.06 | 1.393 | 1311.586 | / |
| 25 | Limonene-1,2-epoxide (Fr.1) | 49.676 | 0.454 | 1353.8 | / |
| 26 | Pulegone | 51.84 | 0.214 | 1388.72 | 1237 |
| 27 | Hydroxy-α-terpenyl Acetate | 52.549 | 0.987 | 1395.047 | / |
| 28 | Carvone Acetate | 54.878 | 0.91 | 1434.555 | / |
| Strains | Species | Elattaria cardamomum EO (10 mg/mL) | MFC/MIC Ratio | Itraconazole (10 mg/mL) | MFC/MIC Ratio | ||||
|---|---|---|---|---|---|---|---|---|---|
| IZ* ± SD* (mm) | MIC* (mg/mL) | MFC* (mg/mL) | IZ ± SD (mm) | MIC (mg/mL) | MFC (mg/mL) | ||||
| A1 | C. utilis ATCC 9255 | 11.66 ± 0.57 a | 0.78 | 100 | >4;Fungistatic | 6 ± 0 a | 0.156 | 2.5 | >4;Fungistatic |
| A15 | C. albicans ATCC 20402 | 10.66 ± 0.57 ab | 0.156 | 100 | >4;Fungistatic | 14.66 ± 0.57 a | 0.078 | 10 | >4;Fungistatic |
| 109 | C. albicans | 8 ± 0 bc | 0.097 | 100 | >4;Fungistatic | 7.33 ± 0.57 a | 0.156 | 2.5 | >4;Fungistatic |
| 113 | C. albicans | 8.66 ± 0.57 cd | 0.156 | 100 | >4;Fungistatic | 6 ± 0 b | 0.312 | 10 | >4;Fungistatic |
| 126 | C. albicans | 9.66 ± 0.57 d | 0.126 | 12.5 | >4;Fungistatic | 11.66 ± 0.57 b | 0.312 | 10 | >4;Fungistatic |
| 104W | C. albicans | 9.66 ± 0.57 d | 0.156 | 50 | >4;Fungistatic | 10.33 ± 0.57 c | 0.312 | 10 | >4;Fungistatic |
| C4 | C. albicans | 9.66 ± 0.57 d | 0.156 | 100 | >4;Fungistatic | 6 ± 0 c | 0.312 | 10 | >4;Fungistatic |
| C5 | C. albicans | 7.33 ± 0.57 e | 0.156 | 25 | >4;Fungistatic | 7.33 ± 0.57 d | 0.078 | 10 | >4;Fungistatic |
| C1 | C. albicans | 9 ± 0 f | 0.156 | 50 | >4;Fungistatic | 10.33 ± 0.57 e | 0.312 | 10 | >4;Fungistatic |
| Strains | Concentration | Phospholipase | Proteinase | ||
|---|---|---|---|---|---|
| OD*570 nm ± SD* | Activity | OD*570 nm ± SD* | Activity | ||
| A15 | Blank* | 0.45 ± 0.069 | Very strong | 0.77 ± 0 | High |
| MIC | 0.49 ± 0.05 | Very strong | 1 ± 0 | Very low | |
| 2xMIC | 0.58 ± 0.09 | Very strong | 1 ± 0 | Very low | |
| 4xMIC | 0.62 ± 0.03 | Very strong | 1 ± 0 | Very low | |
| 109 | Blank | 0.76 ± 0.04 | Strong | 0.69 ± 0.09 | Very high |
| MIC | 1 ± 0 | Negative | 0.82 ± 0.03 | Low | |
| 2xMIC | 1 ± 0 | Negative | 1 ± 0 | Very low | |
| 4xMIC | 1 ± 0 | Negative | 1 ± 0 | Very low | |
| 113 | Blank | 0.6 ± 0.005 | Very strong | 0.68 ± 0 | Very high |
| MIC | 0.67 ± 0.03 | Strong | 0.87 ± 0.03 | Low | |
| 2xMIC | 0.69 ± 0.04 | Strong | 1 ± 0 | Very low | |
| 4xMIC | 0.73 ± 0.03 | Strong | 1 ± 0 | Very low | |
| 126 | Blank | 0.61 ± 0 | Very strong | 0.65 ± 0.01 | Very high |
| MIC | 0.9 ± 0 | Strong | 0.67 ± 0.02 | Very high | |
| 2xMIC | 1 ± 0 | Negative | 0.75 ± 0.04 | High | |
| 4xMIC | 1 ± 0 | Negative | 0.7 ± 0.03 | High | |
| Strains | Adhesion to Glass | Slime on CRA* | Biofilm on Polystyrene | ||
|---|---|---|---|---|---|
| Morphotype | S+*/S-* | OD*± SD* | Biofilm Ability | ||
| A1 | + | White | S- | 1.81 ± 0.05 a | Strong biofilm |
| A4 | ++ | Pink | S- | 0.34 ± 0.07 a | Moderate biofilm |
| A8 | +++ | Red | S- | 0.81 ± 0.05 b | Moderate biofilm |
| A9 | ++ | Red | S- | 0.7 ± 0.01 b | Moderate biofilm |
| A10 | +++ | Pink | S- | 0.43 ± 0.03 bc | Moderate biofilm |
| A14 | ++ | Red | S- | 0.77 ± 0.03 bc | Moderate biofilm |
| A15 | ++ | Red | S- | 1.07 ± 0.06 cd | Strong biofilm |
| 124 | +++ | Red with black center | S+ | 0.56 ± 0.09 cde | Moderate biofilm |
| C3 | ++ | Pink | S- | 1.55 ± 0.17 def | Strong biofilm |
| C2 | ++ | Pink | S- | 0.55 ± 0.09 ef | Moderate biofilm |
| 109 | ++ | Pink | S- | 0.66 ± 0.1 f | Moderate biofilm |
| 113 | +++ | Pink | S- | 1.18 ± 0.06 f | Strong biofilm |
| 104 | +++ | Pink | S- | 0.66 ± 0.1 g | Moderate biofilm |
| 126 | +++ | Red | S- | 0.92 ± 0.04 h | Moderate biofilm |
| 104W | ++ | Pink | S- | 0.82 ± 0.04 i | Moderate biofilm |
| C4 | + | White | S- | 1.66 ± 0.1 j | Strong biofilm |
| 108 | + | White | S- | 0.92 ± 0.04 j | Moderate biofilm |
| 118 | + | Pink | S- | 2.17 ± 0.2 k | Strong biofilm |
| C5 | ++ | Bordeaux | S- | 1.68 ± 0.2 l | Strong biofilm |
| C1 | ++ | White | S- | 2.33 ± 0.11 m | Strong biofilm |
| Strains | Concentration | OD*570 nm ± SD* | Biofilm Ability |
|---|---|---|---|
| A1 | Blank* | 0.81 ± 0.05 a | Strong biofilm |
| 1/2× MIC* | 0.7 ± 0.01 a | Moderate biofilm | |
| MIC | 0.43 ± 0.03 b | Moderate biofilm | |
| 2× MIC | 0.092 ± 0.004 c | Low biofilm | |
| 4× MIC | 0.07 ± 0.009 d | Low biofilm | |
| A15 | Blank | 1.07 ± 0.06 a | Strong biofilm |
| 1/2× MIC | 0.92 ± 0.04 a | Moderate biofilm | |
| MIC | 0.82 ± 0.04 b | Moderate biofilm | |
| 2× MIC | 0.095 ± 0.004 c | Low biofilm | |
| 4× MIC | 0.078 ± 0.008 d | Low biofilm | |
| C4 | Blank | 0.66 ± 0.1 a | Strong biofilm |
| 1/2× MIC | 0.55 ± 0.09 a | Moderate biofilm | |
| MIC | 0.08 ± 0 a | Low biofilm | |
| 2× MIC | 0.06 ± 0.01 b | Low biofilm | |
| 4× MIC | 0.03 ± 0.02 c | Low biofilm | |
| C5 | Blank | 1.68 ± 0.2 a | Strong biofilm |
| 1/2× MIC | 1.57 ± 0.19 ab | Strong biofilm | |
| MIC | 1.33 ± 0.17 bc | Strong biofilm | |
| 2× MIC | 1.17 ± 0.19 bd | Strong biofilm | |
| 4× MIC | 0.92 ± 0.18 d | Moderate biofilm | |
| 113 | Blank | 1.18 ± 0.06 a | Strong biofilm |
| 1/2× MIC | 1.08 ± 0.01 b | Strong biofilm | |
| MIC | 0.942 ± 0.05 c | Moderate biofilm | |
| 2× MIC | 0.782 ± 0.04 d | Moderate biofilm | |
| 4× MIC | 0.58 ± 0.03 e | Moderate biofilm |
Publisher’s Note: MDPI stays neutral with regard to jurisdictional claims in published maps and institutional affiliations. |
© 2022 by the authors. Licensee MDPI, Basel, Switzerland. This article is an open access article distributed under the terms and conditions of the Creative Commons Attribution (CC BY) license (https://creativecommons.org/licenses/by/4.0/).
Share and Cite
Noumi, E.; Alshammari, G.S.; Zmantar, T.; Bazaid, A.S.; Alabbosh, K.F.; Elasbali, A.M.; Abu Al-Soud, W.; Ghazi Alrashidi, S.; Snoussi, M. Antibiofilm Potential and Exoenzyme Inhibition by Elattaria cardamomum Essential Oil in Candida spp. Strains. Life 2022, 12, 1756. https://doi.org/10.3390/life12111756
Noumi E, Alshammari GS, Zmantar T, Bazaid AS, Alabbosh KF, Elasbali AM, Abu Al-Soud W, Ghazi Alrashidi S, Snoussi M. Antibiofilm Potential and Exoenzyme Inhibition by Elattaria cardamomum Essential Oil in Candida spp. Strains. Life. 2022; 12(11):1756. https://doi.org/10.3390/life12111756
Chicago/Turabian StyleNoumi, Emira, Ghada Salamah Alshammari, Tarek Zmantar, Abdulrahman S. Bazaid, Khulood Fahad Alabbosh, Abdelbaset Mohamed Elasbali, Waleed Abu Al-Soud, Sami Ghazi Alrashidi, and Mejdi Snoussi. 2022. "Antibiofilm Potential and Exoenzyme Inhibition by Elattaria cardamomum Essential Oil in Candida spp. Strains" Life 12, no. 11: 1756. https://doi.org/10.3390/life12111756
APA StyleNoumi, E., Alshammari, G. S., Zmantar, T., Bazaid, A. S., Alabbosh, K. F., Elasbali, A. M., Abu Al-Soud, W., Ghazi Alrashidi, S., & Snoussi, M. (2022). Antibiofilm Potential and Exoenzyme Inhibition by Elattaria cardamomum Essential Oil in Candida spp. Strains. Life, 12(11), 1756. https://doi.org/10.3390/life12111756

